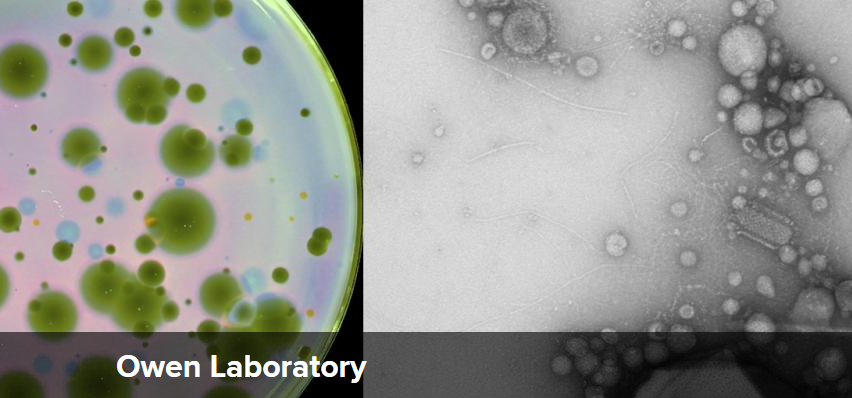

Tiffany Taylor
@taylorlabgroup
Prof Microbial Ecology & Evolution @LifeSciencesBath. @RoyalSociety Dorothy Hodgkin Research Fellow. Children's author evolution/genetics. Mum. Same name on 💙☁
ID: 195685539
https://tiffanybtaylor.wordpress.com/ 27-09-2010 10:05:28
1,1K Tweet
1,1K Followers
1,1K Following

My lab is up and running and just needs enthusiastic phage biologists to populate it! Contact me or apply in the link if you are interested in a postdoc exploring plasmid-dependent phage biology in beautiful (and super affordable!) upstate New York🍎healthresearch.wd1.myworkdayjobs.com/en-US/HRI_Care… 1/3

Hooray 🎉 Josie Elliott, who passed her PhD viva with flying colours. Many thanks to examiners Jamie Hall & Zamin Iqbal. Josie was cosupervised by edze westra, & will soon start her postdoc with Anne Chevallereau. I'm so sad to see her go, but excited to see what's next. Go get 'em Dr Elliott



🚨Interested in #evolution and #synbio and looking for a PhD? Then come join mine, Tiffany Taylor and Jordi Paps labs to trace and shape the evolutionary paths of engineered biology! 🛠️🧬🧪 Project details here: bpb-eu-w2.wpmucdn.com/blogs.bristol.…, apply here: swbio.ac.uk/programme/how-…


Microbe of the Month featuring Pseudomonas fluorescens By Tiffany B. Taylor (Tiffany Taylor), Mark W. Silby (Mark Silby) & Robert W. Jackson (Robert Jackson) dlvr.it/TGVgb4





Ever heard of Palindromic DNA? Check this out! I made this with Tiffany Taylor from the Milner Centre for Evolution



Wonderful time catching up with old friends and making new VAAM - Vereinigung f. Allg. u. Ang. Mikrobiologie. Thanks to Susanne for the invitation to open the Evolution of Regulation session. Lots of great science (and 🥨 and🍺).


If you're at Microbiology Society annual conference, go find Maryam Ravari who is presenting her work on mechanisms of biocide tolerance un Proteus mirabilis! #Microbio25


Another poster not to miss Microbiology Society annual conference, Jasmine Thomas-Campbell is presenting her first year PhD work on Determining the regulation of the MADS defence system #Microbio25




Evolution Fact Friday! Did you know that you can see evolution happening in real time? Our fab PhD student Beth Morillo-Hall & fab Tiffany Taylor have developed #Evoscope, an education package for teachers to bring the process of evolution to life in real time bath.ac.uk/campaigns/disc…